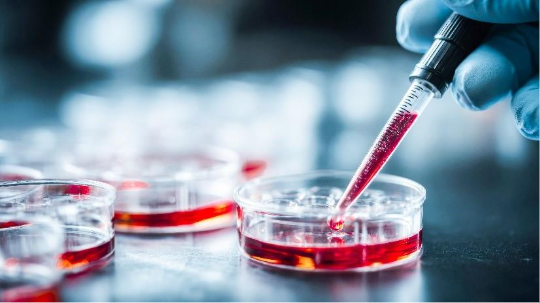
product-thumb

Cell Culture Reagents are essential laboratory solutions and chemicals used to support the growth, maintenance, and processing of cells in research and industrial applications. These reagents help create the right environment for cells to live, divide, and be studied or manipulated under controlled laboratory conditions.
Supports Healthy Cell Growth: Cells require a suitable environment with nutrients and protective components. Reagents like amino acids and glucose help cells survive and proliferate properly.
Improves Experimental Consistency: High‑quality reagents enhance reproducibility, so experiments yield reliable results every time — a must for research and product development.
Enables Cell Preservation: Cryopreservation reagents (like freezing media) help store cells long‑term with minimal loss of viability, which is critical for biobanking and repeat experiments.
Prevents Contamination and Error: Reagents designed for cell culture are sterile and free of contaminants, ensuring that cultures aren’t compromised by bacteria, fungi, RNases, or endotoxins.
Loading products...